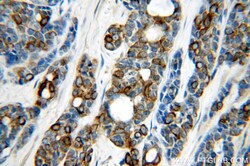

17513-1-AP
antibody from Invitrogen Antibodies
Targeting: KRT7
CK7, K2C7, K7, SCL
Antibody data
- Antibody Data
- Antigen structure
- References [0]
- Comments [0]
- Validations
- Western blot [3]
- Immunocytochemistry [1]
- Immunohistochemistry [10]
- Flow cytometry [1]
- Other assay [1]
Submit
Validation data
Reference
Comment
Report error
- Product number
- 17513-1-AP - Provider product page

- Provider
- Invitrogen Antibodies
- Product name
- Cytokeratin 7 Polyclonal Antibody
- Antibody type
- Polyclonal
- Antigen
- Synthetic peptide
- Description
- This antibody is specifically against KRT7.
- Reactivity
- Human
- Host
- Rabbit
- Isotype
- IgG
- Vial size
- 150 µL
- Concentration
- 0.15 mg/mL
- Storage
- -20°C
No comments: Submit comment
Supportive validation
- Submitted by
- Invitrogen Antibodies (provider)
- Main image

- Experimental details
- HeLa cells were subjected to SDS PAGE followed by western blot with 17513-1-AP (Cytokeratin 7-specific antibody at dilution of 1:1000 incubated at room temperature for 1.5 hours.
- Submitted by
- Invitrogen Antibodies (provider)
- Main image

- Experimental details
- HepG2 cells were subjected to SDS PAGE followed by western blot with 17513-1-AP (Cytokeratin 7-specific antibody at dilution of 1:1000 incubated at room temperature for 1.5 hours.
- Submitted by
- Invitrogen Antibodies (provider)
- Main image

- Experimental details
- A431 cells were subjected to SDS PAGE followed by western blot with 17513-1-AP ( Cytokeratin 7-specific antibody at dilution of 1:1000 incubated at room temperature for 1.5 hours.
Supportive validation
- Submitted by
- Invitrogen Antibodies (provider)
- Main image

- Experimental details
- Immunofluorescent analysis of HepG2 cells using 17513-1-AP (Cytokeratin 7-specific antibody) at dilution of 1:50 and Alexa Fluor 488-conjugated AffiniPure Goat Anti-Rabbit IGG (H+L).
Supportive validation
- Submitted by
- Invitrogen Antibodies (provider)
- Main image

- Experimental details
- Immunohistochemistry of paraffin-embedded human lung cancer using 17513-1-AP (KRT7-Specific antibody) at dilution of 1:50 (under 10x lens).
- Submitted by
- Invitrogen Antibodies (provider)
- Main image

- Experimental details
- Immunohistochemistry of paraffin-embedded human lung cancer using 17513-1-AP (KRT7-Specific antibody) at dilution of 1:50 (under 40x lens).
- Submitted by
- Invitrogen Antibodies (provider)
- Main image

- Experimental details
- Immunohistochemistry of paraffin-embedded human cervical cancer using 17513-1-AP (KRT7-Specific antibody) at dilution of 1:50 (under 10x lens).
- Submitted by
- Invitrogen Antibodies (provider)
- Main image
- Experimental details
- Immunohistochemistry of paraffin-embedded human cervical cancer using 17513-1-AP (KRT7-Specific antibody) at dilution of 1:50 (under 40x lens).
- Submitted by
- Invitrogen Antibodies (provider)
- Main image

- Experimental details
- Immunohistochemistry of paraffin-embedded human ovary tumor tissue slide using 17513-1-AP (Cytokeratin 7-specific antibody at dilution of 1:50 (under 10x lens).
- Submitted by
- Invitrogen Antibodies (provider)
- Main image

- Experimental details
- Immunohistochemistry of paraffin-embedded human ovary tumor tissue slide using 17513-1-AP (Cytokeratin 7-specific antibody at dilution of 1:50 (under 40x lens).
- Submitted by
- Invitrogen Antibodies (provider)
- Main image

- Experimental details
- Immunohistochemistry of paraffin-embedded human lung cancer tissue slide using 17513-1-AP (Cytokeratin 7-specific antibody at dilution of 1:200 (under 10x lens). heat mediated antigen retrieved with Tris-EDTA buffer (pH 9).
- Submitted by
- Invitrogen Antibodies (provider)
- Main image

- Experimental details
- Immunohistochemistry of paraffin-embedded human lung cancer tissue slide using 17513-1-AP (Cytokeratin 7-specific antibody at dilution of 1:200 (under 40x lens). heat mediated antigen retrieved with Tris-EDTA buffer (pH 9).
- Submitted by
- Invitrogen Antibodies (provider)
- Main image

- Experimental details
- Immunohistochemistry of paraffin-embedded human breast cancer tissue slide using 17513-1-AP ( Cytokeratin 7-specific antibody at dilution of 1:50 (under 10x lens).
- Submitted by
- Invitrogen Antibodies (provider)
- Main image

- Experimental details
- Immunohistochemistry of paraffin-embedded human breast cancer tissue slide using 17513-1-AP ( Cytokeratin 7-specific antibody at dilution of 1:50 (under 40x lens).
Supportive validation
- Submitted by
- Invitrogen Antibodies (provider)
- Main image

- Experimental details
- 1X10^6 HeLa cells were intracellularly stained with 0.2 µg Anti-Human Cytokeratin 7-specific (Product # 17513-1-AP) and CoraLite®488-Conjugated AffiniPure Goat Anti-Rabbit IgG(H+L) at dilution 1:1,000 (red), or 0.2 µg Control Antibody. Cells were fixed with 4% PFA and permeabilized with Flow Cytometry Perm Buffer (PF00011-C).
Supportive validation
- Submitted by
- Invitrogen Antibodies (provider)
- Main image

- Experimental details
- IP result of anti-Cytokeratin 7-specific (IP:17513-1-AP, 4ug; Detection:17513-1-AP 1:1000) with HepG2 cells lysate 3600ug.